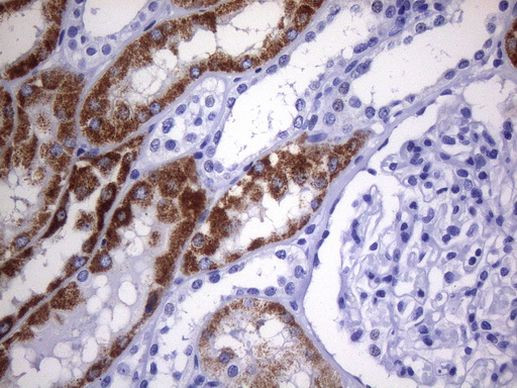
AMACR Antibody in Immunohistochemistry (Paraffin) (IHC (P))

Search
OriGene
AMACR Monoclonal Antibody (UMAB214), UltraMAB™
{{$productOrderCtrl.translations['antibody.pdp.commerceCard.promotion.promotions']}}
{{$productOrderCtrl.translations['antibody.pdp.commerceCard.promotion.viewpromo']}}
{{$productOrderCtrl.translations['antibody.pdp.commerceCard.promotion.promocode']}}: {{promo.promoCode}} {{promo.promoTitle}} {{promo.promoDescription}}. {{$productOrderCtrl.translations['antibody.pdp.commerceCard.promotion.learnmore']}}
图: 1 / 3
AMACR Antibody (UM800106) in IHC (P)



产品信息
UM800106
种属反应
宿主/亚型
分类
类型
克隆号
抗原
偶联物
形式
浓度
纯化类型
保存液
内含物
保存条件
运输条件
靶标信息
P504S/AMACR/a-Methylacyl-CoA Racemase is an essential enzyme in the b-oxidation of branched-chain fatty acids. High expression of P504S protein is found in prostatic adenocarcinoma but not in benign prostate tissue by immunohistochemical staining in paraffin-embedded tissue. The expression of P504S is also detected in two premalignant lesions of the prostate: high-grade prostatic intraepithelial neoplasia (PIN) and atypical adenomatous hyperplasia.
仅用于科研。不用于诊断过程。未经明确授权不得转售。
篇参考文献 (0)
生物信息学
蛋白别名: 2-methylacyl-CoA racemase; Alpha-methylacyl-CoA racemase; amcr; OTTHUMP00000219978; OTTHUMP00000219979
基因别名: AMACR; AMACRD; CBAS4; RACE; RM
UniProt ID: (Human) Q9UHK6
Entrez Gene ID: (Human) 23600